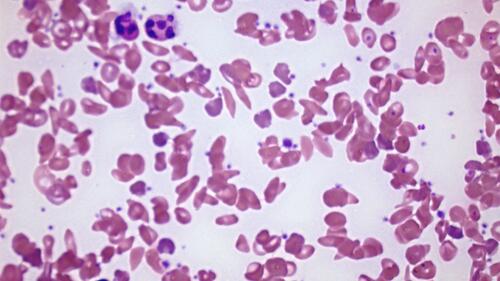

01.04.2024
Chronisch kranke Kinder dürfen nicht vergessen gehen
Menschen mit schweren chronischen nicht-übertragbare Krankheiten brauchen eine frühe Diagnose und dann eine konsequente Behandlung. Gerade für Kinder wie Tawonashe ist das wichtig.
«Aufgrund der Spital- und Medikamentenkosten hatten wir irgendwann kaum noch genug Geld für Nahrungsmittel für die ganze Familie. Unsere Monatslöhne von zusammen ungefähr 250 Franken sind nicht genug, um gleichzeitig die fünfköpfige Familie zu ernähren und die Spitalrechnungen zu zahlen», erinnert sich Stella Magura, die Mutter von Tawonashe, an die Zeit, bevor ihr Sohn Teil des SolidarMed-Projektes war. Der heute zehnjährige Junge hatte schon seit Geburt viele medizinische Probleme, so dass er Dauergast im Spital war. Obwohl seine Symptome jeweils so gut wie möglich behandelt wurden, konnte nie eine richtige Diagnose gestellt werden.
«Unsere Monatslöhne von zusammen ungefähr 250 Franken sind nicht genug, um gleichzeitig die fünfköpfige Familie zu ernähren und die Spitalrechnungen zu zahlen.»
Stella Magura, Mutter von Tawonashe
Als der Junge neun Monate alt war, waren bereits drei Familienmitglieder an der Sichelzellkrankheit gestorben, erzählte seine Tante, die als Pflegefachkraft arbeitet. Auch Tawonashe wurde positiv auf die Hämoglobinerkrankung getestet. Das erklärte seine Schwierigkeiten beim Atmen, die Gelbsucht, seine Abgeschlagenheit und chronischen Körperschmerzen.
Nachdem Tawonashe die Diagnose erhalten hatte, begann im Masvingo-Provinzspital seine Behandlung. Die Aufenthalte im Krankenhaus wurden seltener und er hatte weniger Schmerzen. Doch in der Spitalapotheke waren die Sichelzellmedikamente oft nicht verfügbar, so dass seine Eltern sie für mindestens 25 Franken im Monat in einer privaten Apotheke kaufen mussten. Manchmal fehlte das Geld, und Tawonashe bekam keine oder zu wenig Medizin. Er wurde immer wieder hospitalisiert, weil er Schmerzen hatte, nicht richtig atmen konnte oder Blutarmut aufwies. Dazu wurde bei ihm 2022 noch die Diagnose Diabetes Typ 1 gestellt.
Die Sichelzellkrankheit ist eine genetisch vererbte Veränderung der roten Blutkörperchen von einer glatten, donutförmigen Form in eine Halbmondform. Die falsch geformten Zellen können kleine Blutgefässe blockieren, was den Blutfluss beeinträchtigt.
Aufgrund fehlender Geräte, Medikamente und ausgebildeten Gesundheitspersonals werden Menschen mit schweren chronischen, nicht-übertragbaren Krankheiten in Simbabwe oft weder korrekt diagnostiziert noch behandelt. Bluthochdruck, Diabetes, Krebs oder Atemwegserkrankungen sind nicht-übertragbare Krankheiten, die zusammen für einen Drittel der Todesfälle im Land verantwortlich sind. Diagnose- und Behandlungsmöglichkeiten gibt es oft nur in städtischen Zentren, was den Zugang für die arme Landbevölkerung unmöglich macht.
Für Kinder sind chronische Krankheiten gleich zweifach schwierig. Einerseits leiden sie unter den gesundheitlichen Problemen, andererseits werden ihre Zukunftschancen eingeschränkt, weil sie Schulzeit verpassen und Schwierigkeiten haben, am sozialen Leben teilzunehmen und später Teil der Gesellschaft zu sein. Die meisten Bestrebungen in diesem Bereich haben aber Erwachsene als Zielgruppe.
Auch das Projekt von SolidarMed setzt erst bei den Erwachsenen an. Zusammen mit der Weltgesundheitsorganisation (WHO) und der Organisation Partners in Health wird darauf hingearbeitet, schwere nicht-übertragbare Krankheiten in der medizinischen Grundversorgung zu verankern. Die Initiative soll mittels standardisierter Programme genügend und geeignete Medikamente, Technologien und Diagnosemöglichkeiten zur Verfügung stellen. Damit soll die Lebensqualität der Patient:innen verbessert und die Anzahl neu Betroffener reduziert werden.
Nachdem SolidarMed verschiedene Gesundheitseinrichtungen untersucht hatte, wurde klar, dass sich sowohl das Gesundheitsministerium wie auch andere Organisationen vor allem auf ansteckende Krankheiten wie Tuberkulose, Malaria oder HIV konzentrieren. SolidarMed baut nun zusammen mit dem Ministerium für Gesundheit und Kinderbetreuung das Programm in vier Stufen auf: Als Erstes hat SolidarMed entsprechende Abteilungen im Masvingo-Provinzspital, im Mashoko- und Ndanga-Distriktspital aufgebaut. Dazu wurden die Räume renoviert und spezialisierte Diagnosegeräte angeschafft. Bis jetzt werden in den drei Kliniken über 500 Personen für Krankheiten wie Herzfehler, Typ-1-Diabetes, Asthma, Epilepsie und Sichelzellkrankheit behandelt. Einer dieser Patient:innen ist Tawonashe.
Im Masvingo-Provinzspital, in dem auch der Junge diagnostiziert und behandelt wird, wurden als Zweites Ausbildungsmöglichkeiten geschaffen. 45 Gesundheitsfachkräfte lernen hier, wie diese nicht-übertragbaren Krankheiten behandelt werden. Neben der nationalen Weiterbildung in Masvingo wurden auch zweiwöchige klinische Praktikumsprogramme ins Leben gerufen. Damit werden den Pflegenden und Assistenzärzt:innen praktische Erfahrungen ermöglicht. Ein wichtiger Teil der Weiterbildung ist, den Teilnehmenden eine wertfreie Sprache mitzugeben und die Patient:innen darin zu bestärken, langfristig die Verantwortung für ihre Gesundheit zu übernehmen.

Der zehnjährige Tawonashe und seiner Mutter Stella Magura haben wieder Hoffnung geschöpft.
Um die Verbesserungen messen zu können, wird Ende dieses Jahres untersucht, wie sich die Versorgung der Betroffenen verändert hat und wie es um die Machbarkeit und Akzeptanz in den Spitälern steht. Mit diesen Informationen werden SolidarMed und die Gesundheitsbehörden Schlüsse darüber ziehen können, wie das Programm am besten in weiteren Umgebungen Simbabwes eingeführt werden kann. Ziel ist es, zusammen mit Partnerorganisationen wie der Clinton Health Access Initiative (CHAI) einen Plan zu entwickeln, um das Programm sogar auf nationaler Ebene auszurollen.
Seit vergangenem Juni wird Tawonashe dank SolidarMed im Masvingo-Provinzspital behandelt. Er profitiert nun von konstanter Medikation wie Insulin, Schmerzmitteln und Medizin gegen seine Sichelzellkrankheit. Dabei sind Labor- und Röntgenuntersuchungen und das generelle Gesundheitswissen des ausgebildeten Pflegepersonals entscheidend. «Ich dachte immer, die Sichelzellkrankheit sei sein Todesurteil, aber jetzt haben wir Hoffnung», betont Tawonashes Mutter.
«Danke! Mein Traum, Arzt zu werden, wird wegen Euch in Erfüllung gehen.»
Tawonashe Magura, zehnjähriger Patient
Damit möglichst viel Gesundheitspersonal das nötige Wissen hat, um mehr Kinder wie Tawonashe zu behandeln, baut SolidarMed bis Ende Jahr die zwei anderen Spitäler so aus, dass sie Praktikas anbieten können. Gleichzeitig legt SolidarMed mit dem Ausbau des Projekts ein besonderes Augenmerk auf die jungen Patient:innen, denn diese Gruppe mit ihren spezifischen Bedürfnissen wurde bisher vernachlässigt.
Die Projektspitäler werden nun darin gestärkt, diese schweren chronischen Krankheiten schon früh zu erkennen und zu behandeln. Ausserdem werden eigene Abteilungen eingerichtet, in denen die Kinder und Jugendlichen unter sich sind und sich wohl fühlen. Damit sollen auch potenzielle Ansteckungen vermieden werden. Der Ausbau ist ein Beitrag zu einer gerechteren Gesundheitsversorgung. Und vielleicht, in einigen Jahren, wird Tawonashe gleich selbst hier arbeiten: «Danke! Mein Traum, Arzt zu werden, wird wegen Euch in Erfüllung gehen», freut sich der Zehnjährige.
Gemeinsam gegen Diabetes
Diabetes ist eine der häufigsten nicht-übertragbaren Krankheiten weltweit. In Simbabwe und Lesotho arbeitet SolidarMed mit der Stiftung «World Diabetes Foundation» zusammen, um Menschen in ländlichen Regionen Zugang zu Prävention, Diagnose und Behandlung der Krankheit zu verschaffen.